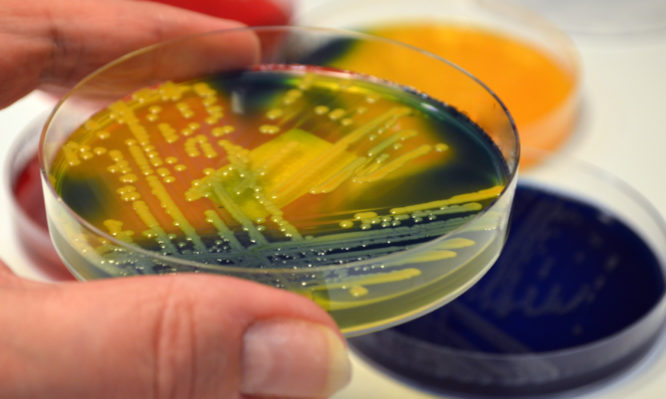

Candida auris: Ποιος είναι ο μύκητας με «προίκα» ποσοστό θνησιμότητας έως 40% – Τι ισχύει στην Ελλάδα
Έντονο προβληματισμό στους ειδικούς προκαλεί ο μύκητας candida auris, αναφορικά με τον τρόπο της ταυτοποίησής τους, παρόλο που ακόμη επικρατεί σχετική ηρεμία για την χώρα μας
Έντονο προβληματισμό στους ειδικούς προκαλεί ο μύκητας candida auris, αναφορικά με τον τρόπο της ταυτοποίησής τους, παρόλο που ακόμη επικρατεί σχετική ηρεμία για την χώρα μας.
«Προς το παρόν δεν έχουμε λόγο πανικού, γιατί στην Ελλάδα δεν έχει εμφανιστεί. Πρέπει όμως οι επαγγελματίες υγείας να είμαστε σε εγρήγορση, γιατί είναι ένα παθογόνο, το οποίο αφενός είναι πολυανθεκτικό, αφετέρου έχει προκαλέσει επιδημίες σε νοσοκομεία» δηλώνει για τον μύκητα candida auris στο Πρακτορείο FM και στην εκπομπή της Τάνιας Η. Μαντουβάλου «104,9 ΜΥΣΤΙΚΑ ΥΓΕΙΑΣ» που θα μεταδοθεί το Σάββατο 18 Απριλίου, η υπεύθυνη Γραφείου Νοσοκομειακών Λοιμώξεων και Μικροβιακής Αντοχής του ΕΟΔΥ (Εθνικός Οργανισμός Δημόσιας Υγείας- πρώην ΚΕΕΛΠΝΟ) Φλώρα Κοντοπίδου.
«Άμεσα πρόκειται να αποσταλούν από τον ΕΟΔΥ οδηγίες στα νοσοκομεία, ενώ έχουν ήδη γίνει από την Εταιρεία Βιοπαθολογίας και την Εταιρεία Μυκητολογίας ειδικά σεμινάρια στους εργαστηριακούς γιατρούς των νοσοκομείων, ώστε να ευαισθητοποιηθούν στο πότε πρέπει να υποπτεύονται ότι πρόκειται για το συγκεκριμένο μύκητα» αναφέρει η παθολόγος – λοιμωξιολόγος.
Μάλιστα, η ίδια εξηγεί ότι η ταυτοποίησή του είναι το βασικό μέτρο πρόληψης, επειδή είναι δύσκολη, γιατί εμφανίζει αντοχή σε σοβαρές κατηγορίες φαρμάκων. «Αυτό που παίζει μεγάλο ρόλο είναι η σωστή θεραπευτική αντιμετώπιση του ασθενή, γιατί αν δεν υπάρχει άμεση ταυτοποίηση, μία λάθος θεραπεία μπορεί να οδηγήσει σε άσχημη έκβαση. Επίσης ο καθαρισμός του νοσοκομειακού περιβάλλοντος είναι ένα κομμάτι αυτής της πρόληψης».
Στo 30-40% η θνητότητα
Ο candida auris όπως λέει η κα Κοντοπίδου είναι ένας μύκητας, ο οποίος μεταδίδεται όπως μεταδίδονται και τα απλά βακτήρια μέσα στα νοσοκομεία, κυρίως με την επαφή.
«Επιμολύνει επιφάνειες ή εξοπλισμό και με αυτό τον τρόπο μπορεί να μεταφερθεί από ασθενή σε ασθενή. Πολλές φορές μάλιστα επιβιώνει για αρκετό χρονικό διάστημα στις επιφάνειες και μπορεί να βρεθεί και σε απομακρυσμένα από τον ασθενή σημεία. Για αυτό και ο καθαρισμός του νοσοκομειακού περιβάλλοντος αποτελεί σημαντικό μέρος της πρόληψης, για τον έλεγχο της διασποράς μέσα στο νοσοκομείο. Το πρώτο και το σημαντικό όμως είναι η ευαισθητοποίηση των μικροβιολογικών εργαστηρίων και για αυτό έχουμε προχωρήσει σε οδηγίες, οι οποίες σύντομα θα αποσταλούν στα νοσοκομεία».
Ο μύκητας προκαλεί σοβαρές λοιμώξεις, όπως πχ λοιμώξεις αίματος και πλήττει κυρίως ευάλωτους ασθενείς, σοβαρά πάσχοντες όπως είναι πχ ανοσοκατεσταλμένοι σε ΜΕΘ, ασθενείς που έχουν ξένα σώματα όπως πχ καθετήρες. Δηλαδή ασθενείς που νοσηλεύονται επί μακρόν, σύμφωνα με την κα Κοντοπίδου. Όσον αφορά τη θνητότητα, σύμφωνα με τις μέχρι στιγμής καταγραφές κυμαίνεται σε 30-40% και σε βαρέως πάσχοντες ασθενείς, μπορεί να αγγίξει το 60%, λέει η λοιμωξιολόγος του ΕΟΔΥ .
Περιστατικά επιδημιών σε Ισπανία, Γαλλία, Αγγλία και Γερμανία
«Ωστόσο αυτοί οι ασθενείς έχουν και άλλους παράγοντες κινδύνου για θνητότητα. Δεν είναι ξεκαθαρισμένο απολύτως αν οφείλεται στο συγκεκριμένο παθογόνο ή στην προτέρα κατάσταση. Δεν υπάρχουν μέχρι τώρα πολλά δεδομένα όσον αφορά τη λοίμωξη, την αντιμετώπιση και την πρόληψη. Και αυτός είναι και ο λόγος που και το Ευρωπαϊκό Κέντρο Ελέγχου και Πρόληψης Νόσων (ECDC) παρόλο που έκανε την εκτίμηση κινδύνου το 2018, ακόμα δεν έχει εκδώσει συγκεκριμένες οδηγίες, τις οποίες περιμέναμε κι εμείς. Εμείς ούτως ή άλλως έχουμε βγάλει οδηγίες, στα βασικά κομμάτια, που θα πάνε όπως σας είπα στα νοσοκομεία. Αλλά υπάρχουν ακόμα κάποια λίγο ασαφή στοιχεία, τα οποία χρειάζονται περισσότερη μελέτη».
Όπως δηλώνει η κα Κοντοπίδου στις ΗΠΑ μέχρι τέλος Φεβρουαρίου το Αμερικανικό Κέντρο Ελέγχου Λοιμώξεων αναφέρει 1.056 ασθενείς που είναι φορείς του συγκεκριμένου μύκητα, εκ των οποίων οι 587 έχουν εμφανίσει επιβεβαιωμένη λοίμωξη.
«Στην Ευρώπη εμφανίζονται περιστατικά επιδημιών σε Ισπανία, Γαλλία, Αγγλία και Γερμανία και σποραδικά κρούσματα σε Αυστρία, Βέλγιο, Σουηδία, Ολλανδία, καθώς επίσης και σε άλλες χώρες του κόσμου».